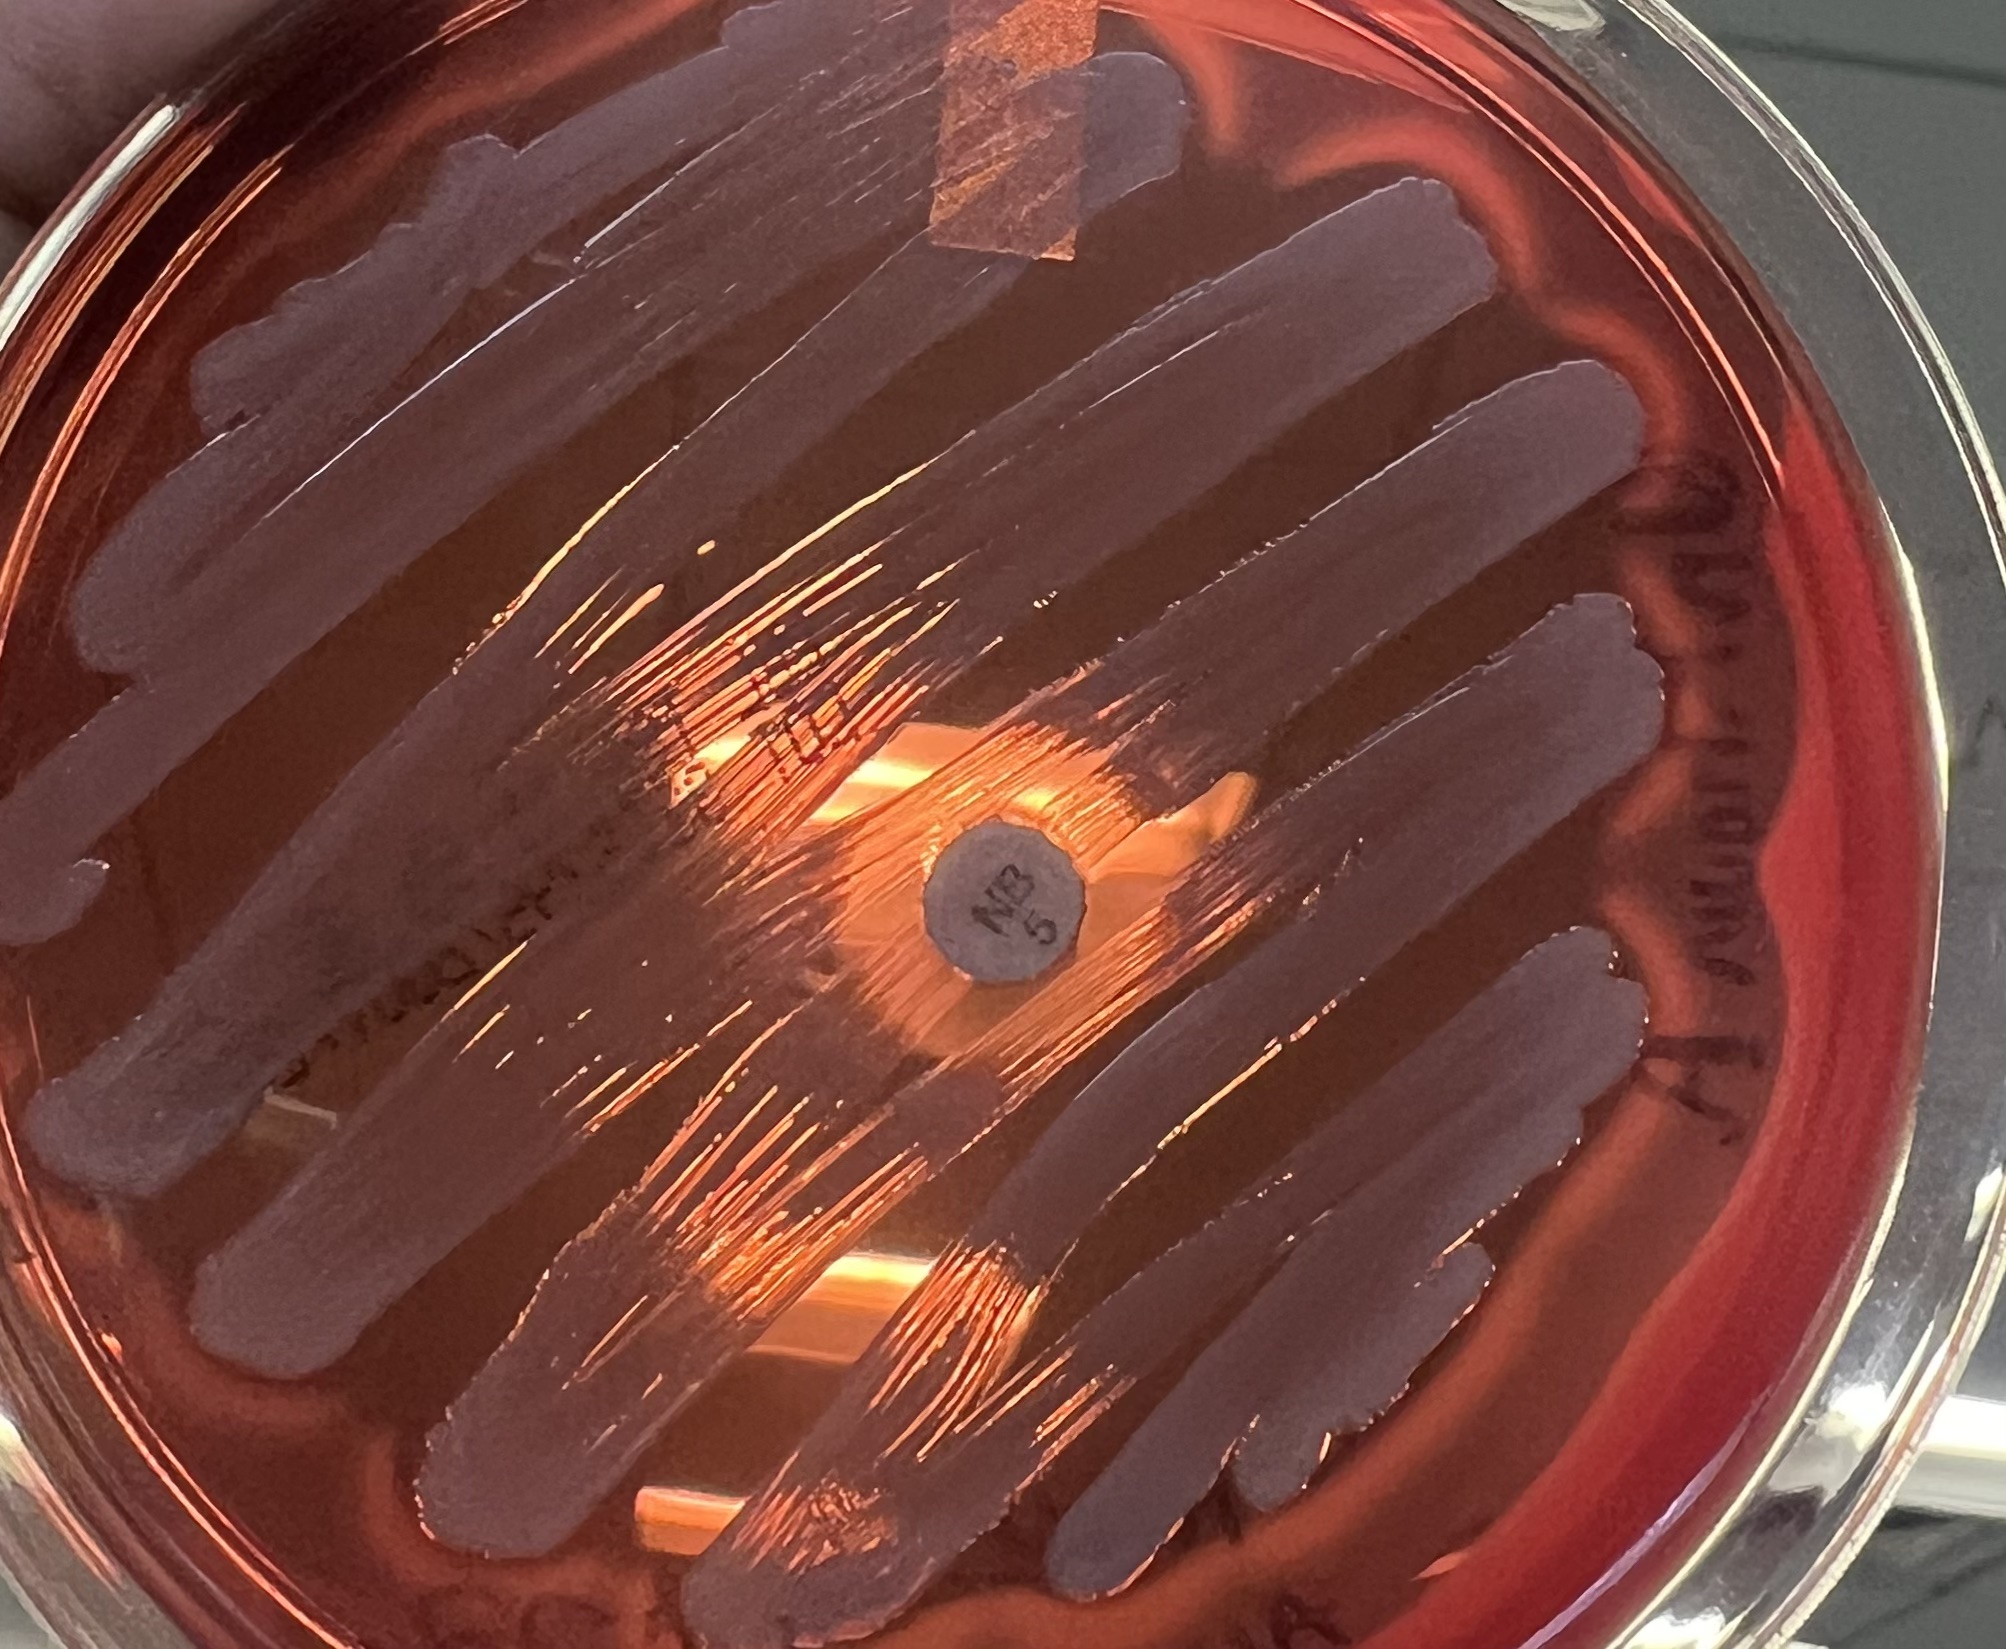
Solved Beta, Alpha, or Gamma Hemolysis? | Chegg.com

Understanding the intricacies of blood typing and hemolysis is crucial for medical professionals, particularly in the fields of hematology and transfusion medicine. One of the key concepts in this area is Alpha Beta Gamma Hemolysis, a term that encompasses the different types of hemolysis that can occur in blood samples. This process is essential for identifying blood types and ensuring compatibility during blood transfusions.
Understanding Hemolysis
Hemolysis refers to the rupture of red blood cells, leading to the release of their contents into the surrounding fluid. This process can occur due to various factors, including mechanical stress, chemical agents, or immunological reactions. In the context of blood typing, hemolysis is a critical consideration because it can affect the accuracy of test results.
Types of Hemolysis
There are three primary types of hemolysis that are relevant to blood typing: Alpha, Beta, and Gamma. Each type has distinct characteristics and implications for medical diagnosis and treatment.
Alpha Hemolysis
Alpha hemolysis, also known as partial hemolysis, occurs when red blood cells are partially lysed, resulting in a greenish discoloration of the blood agar. This type of hemolysis is often observed in the presence of certain bacteria, such as Streptococcus pneumoniae, which produce hydrogen peroxide. The green color is due to the reaction between the hydrogen peroxide and the hemoglobin released from the lysed cells.
Beta Hemolysis
Beta hemolysis, or complete hemolysis, involves the complete lysis of red blood cells, leading to a clear zone around the bacterial colony on blood agar. This type of hemolysis is typically caused by bacteria that produce hemolysins, enzymes that break down the cell membranes of red blood cells. Examples of bacteria that exhibit beta hemolysis include Staphylococcus aureus and Streptococcus pyogenes.
Gamma Hemolysis
Gamma hemolysis, also referred to as no hemolysis, occurs when there is no visible lysis of red blood cells. The blood agar remains unchanged, indicating that the bacteria do not produce hemolysins. This type of hemolysis is often observed with non-pathogenic bacteria, such as Staphylococcus epidermidis.
Importance of Alpha Beta Gamma Hemolysis in Blood Typing
In blood typing, the identification of Alpha Beta Gamma Hemolysis is crucial for determining blood compatibility. The presence or absence of hemolysis can indicate the presence of certain antibodies or antigens on the surface of red blood cells. For example, the presence of alpha hemolysis may suggest the presence of certain antibodies that react with the red blood cells, leading to partial lysis.
Diagnostic Techniques for Identifying Hemolysis
Several diagnostic techniques are used to identify and classify hemolysis in blood samples. These techniques include:
- Blood Agar Plates: Blood agar plates are commonly used to observe the type of hemolysis produced by bacteria. The plates are inoculated with the bacterial sample and incubated. The resulting hemolysis pattern is then observed and classified as alpha, beta, or gamma.
- Coombs Test: The Coombs test, also known as the direct antiglobulin test, is used to detect antibodies or complement proteins on the surface of red blood cells. This test is particularly useful in identifying immune-mediated hemolysis.
- Hemoglobinuria Test: The hemoglobinuria test is used to detect the presence of free hemoglobin in the urine, which is an indicator of hemolysis. This test is often used in conjunction with other diagnostic techniques to confirm the presence of hemolysis.
Clinical Implications of Hemolysis
Hemolysis can have significant clinical implications, particularly in the context of blood transfusions and immune-mediated disorders. Understanding the type of hemolysis is essential for selecting appropriate treatment options and preventing complications.
For example, in the case of immune-mediated hemolysis, such as autoimmune hemolytic anemia, the presence of antibodies on the surface of red blood cells can lead to their destruction. This condition requires careful management to prevent further hemolysis and ensure the patient's well-being.
In the context of blood transfusions, the identification of Alpha Beta Gamma Hemolysis is crucial for ensuring compatibility between the donor and recipient blood types. Incompatible blood transfusions can lead to severe hemolytic reactions, which can be life-threatening. Therefore, accurate identification of hemolysis is essential for preventing such complications.
Preventing Hemolysis in Blood Samples
Preventing hemolysis in blood samples is crucial for obtaining accurate test results. Several measures can be taken to minimize the risk of hemolysis, including:
- Proper Sample Collection: Blood samples should be collected using appropriate techniques to minimize mechanical stress on the red blood cells. This includes using the correct needle size and avoiding excessive suction during blood draw.
- Avoiding Contamination: Blood samples should be handled with care to avoid contamination with chemicals or other substances that can cause hemolysis. This includes using sterile equipment and avoiding exposure to extreme temperatures.
- Prompt Processing: Blood samples should be processed promptly to minimize the risk of hemolysis. Delayed processing can lead to the breakdown of red blood cells, resulting in inaccurate test results.
📝 Note: Proper handling and processing of blood samples are essential for obtaining accurate test results and preventing hemolytic reactions.
Conclusion
Understanding Alpha Beta Gamma Hemolysis is essential for medical professionals involved in blood typing and transfusion medicine. The identification and classification of hemolysis play a crucial role in ensuring blood compatibility and preventing hemolytic reactions. By employing appropriate diagnostic techniques and preventive measures, medical professionals can accurately identify and manage hemolysis, ensuring the safety and well-being of their patients.
Related Terms:
- beta hemolytic vs gamma
- alpha hemolysis vs beta
- three types of hemolysis
- gamma vs alpha hemolysis
- gamma vs beta hemolysis
- hemolysis in sheep blood